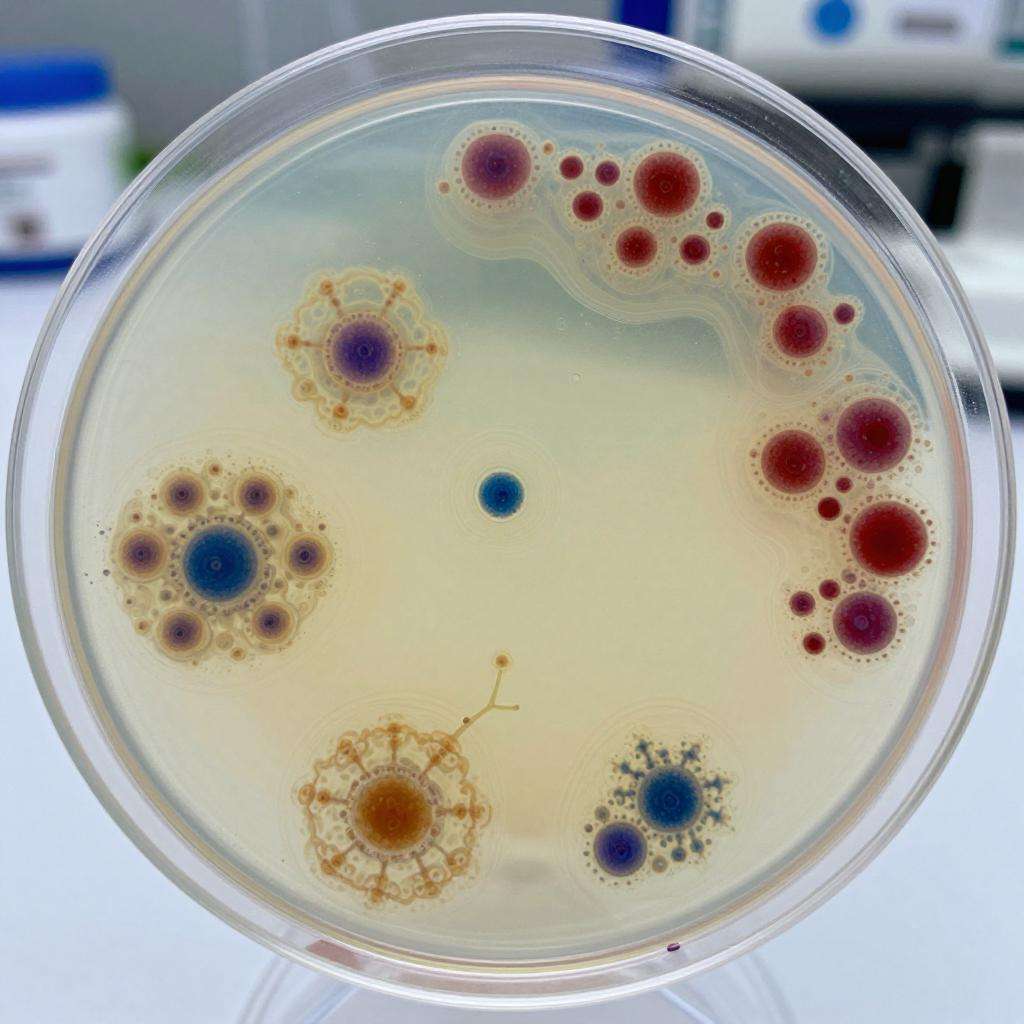
IT通过基因编程细菌活细胞，打印出可以变色的“纹身”第一张图

这项新技术或被应用于芯片晶体管中,以推动“活体计算机”的发展。 近日,麻省理工学院(MIT)的研发人员成功的研发出了一种新的3D打印技术,该技术可以基于“基因编程细菌活细胞”,为用户打印出个性化的“纹身”。 据悉,通过MIT的这一技术打印出来的纹身,可以在某些化学刺激下改变颜色。 该“纹身”的墨水是由经过基因编程的活细胞打造的,当研究人员在人手上对其进行不同目标化学物质的测试时,“纹身”就可以感应到相应的化学物质特性,从而点亮某些颜色。 目前,大多数新材料的研发工作都是基于某些响应类材料的,很少有人会想到利用活细胞进行研究。研究人员表示,为了开拓新的研究方向,他们对活性细胞进行了研究,并发现细菌拥有着强大的细胞壁,抗压性比较高,能够在3D打印的喷嘴下存活下来。此外,细菌还能够与3D打印所用的水凝胶完全相容,是研究人员的绝佳之选。 为了测试这项技术的可行性,研究人员设计了一个类似于树的结构,打印了一张细菌细胞贴纸。试验结果显示,该“树”的每一个“树干”都能在受到不同的化学刺激时显示出不同的颜色。 研究人员表示,他们希望将这项新技术应用于芯片的晶体管,让其成为通信载体,推动“活体计算机”的发展。
未经允许不得转载:医械工坊资讯 » IT通过基因编程细菌活细胞,打印出可以变色的“纹身”